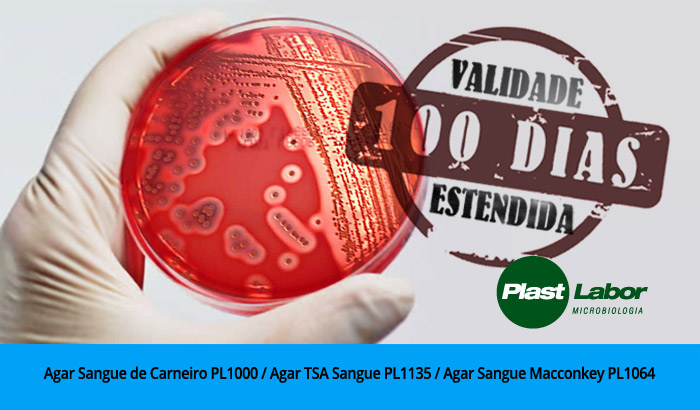

Soluções nacionais no combate à tuberculose

Segundo o último relatório do Ministério da Saúde, cerca de 70 mil casos de tuberculose são registrados anualmente somente no Brasil.
Certificação de qualidade da Plast Labor é renovada

A Plastlabor obteve a renovação da ISO 9001:2015 – 55993-A que atesta sua Gestão em Qualidade na produção de meios de cultura prontos para uso. A certificação é uma comprovação de que a empresa se enquadra nos rígidos padrões de qualidade internacionais e está apta a atender aos mais variados públicos.
Plast Labor desenvolve testes para patógenos prioritários

O aumento de “patógenos prioritários” resistentes aos organismos antimicrobianos é considerado pela Organização Mundial da Saúde (OMS) um novo desafio para pesquisa e desenvolvimento (P&D) de novo fármacos que possam conter essa nova ameaça à saúde pública. No entanto, para que novos antimicrobianos possam ser desenvolvidos são necessários testes como o de Suscetibilidade Antimicrobiana (TSA), que irão apontar como os patógenos irão responder aos antimicrobióticos.
FLYERS MICROBIOLOGICS

Realizamos a tradução para a língua portuguesa do material da Microbiologics.
PLAST LABOR, SUCESSO TOTAL NO 52º CBPC/ML

O 52º Congresso Brasileiro de Patologia Clínica/Medicina Laboratorial (52º CBPC/ML), aconteceu na última semana em Florianópolis. A Plastlabor esteve presente ao evento no stand 38.
COMUNICADO – EXTENSÃO DA VALIDADE
A Plast Labor vem comunicar a extensão da validade para 100 dias dos produtos Agar Sangue de Carneiro PL1000, Agar Sangue Macconkey PL1064 e Agar TSA Sangue PL1135.
WORKSHOP GRATUITO BIOLOGIA MOLECULAR PLASTLABOR – SP 2018

Grandes especialistas nacionais e internacionais em um evento gratuito, com certificado. Contaremos com a presença de Delene Strunge e Kaylan Neson, da Microbiologics, Profº German Sparza da Pontificia Universidad Javeriana in Bogotá Colômbia, Thaís Freitas da Universidade Federal de São Paulo, Paula Célia Mariko Koga e Rubia Anita Ferraz Santana e Dr. Andre Mario Doi do Laboratório do Hospital Israelita Albert Einstein.
PLAST LABOR NO 52º CBPC/ML 2018

O 52º Congresso Brasileiro de Patologia Clínica/Medicina Laboratorial (52º CBPC/ML), acontecerá entre os dias 25 a 28 de setembro de 2018, em Florianópolis. A Plastlabor estará presente ao evento, expondo no stand 38.
WORKSHOPS PLASTLABOR 2018 EM SÃO PAULO

No dia 12 de junho a Plastlabor realizou dois workshops simultâneos em São Paulo, na Faculdade de Ciências Farmacêuticas da USP, sendo um voltado para atuação em Microbiologia Clínica e outro direcionado à Microbiologia Industrial, destacando o tema: Monitoramento Ambiental.
DINÂMICA MOTIVACIONAL E AÇÃO SOCIAL MOVIMENTARAM A FÁBRICA PLASTLABOR NA ÚLTIMA SEMANA

Há mais de um ano toda nossa empresa se comprometeu a colaborar com a Ong One by One na captação de material para reciclagem e lacres de alumínio, que teriam sua renda revertida para a compra de cadeiras de rodas para as crianças do projeto. Desde então, realizamos alguns eventos em conjunto, que muito tem nos alegrado e acrescido.
DIA DA MULHER COM A ONE BY ONE

Em comemoração a semana da mulher, a Plastlabor reuniu mães e filhos atendidos pela ONG ONE by ONE. Estas mulheres especiais receberam manicure, cabeleireira, maquiadora e uma fotógrafa para registrar este dia.
SEMANA DA MULHER PLASTLABOR 2018

Em comemoração à Semana da Mulher 2018, junto com homenagens à mulheres da Ciência, que se destacaram nas áreas da Microbiologia e Saúde, a Plastlabor promoveu também uma ação social.